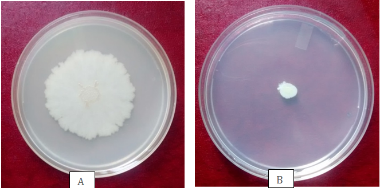

Int J Pharm Pharm Sci, Vol 7, Issue 11, 80-83Original Article
ANTI-QUORUM SENSING ACTIVITY OF SOME COMMONLY USED TRADITIONAL INDIAN SPICES
WALLY MUTUNGWA, NARENDRANATH ALLURI, MALA MAJUMDAR*
Center for Post Graduate Studies, Jain University, 18/3, 9th main, 3rdblock, Jayanagar, Bangalore 560011, India
Email: malamajumdar51@gmail.com
Received: 31 Jul 2015 Revised and Accepted: 10 Sep 2015
ABSTRACT
Objective: To investigate the total phenolic and flavonoids contents and study the anti-quorum sensing activity of Indian spices.
Methods: The methanolic extracts of eight Indian spices were evaluated for phytochemicals and QSI (quorum sensing inhibition). QSI was determined by qualitative and quantitative violacein inhibition using Chromobacterium violaceum12472 as a reporter strain. Biofilm and inhibition of virulence factors viz. EPS (exo poly saccharide production), pyocyanin, proteolytic and swimming motility were assessed against clinically isolated Pseudomonas aeruginosa.
Results: The phytochemical screening of methanolic extract of Indian spices revealed the presence of tannins, flavonoids, terpenoids, cardiac glycosides, carbohydrates, alkaloids and phenolic compounds. Among all the spices, the total phenol (35±0.53 mg/GAE/g DW) and flavonoid (18±0.22 mg/QE/g DW) contents were found to be maximum in Sygygium aromaticum. S. aromaticum exhibited highest quorum sensing(57.63±04%) and biofilm inhibition (49.36±1.5%) at 200 mg/ml. S. aromaticum also showed dose dependent inhibition of virulence factors such as EPS production, pyocyanin, proteolytic and swimming motility against clinically isolated Pseudomonas aeruginosa. ATR-IR (Attenuated total reflectance infrared) analysis of S. aromaticum extract showed phyto constituents with hydroxyl, alkynes, anhydrites, alkene, nitro compounds, aromatics, esters, sulfoxide and halogen functional groups.
Conclusion: The present study promisingly revealed that S. aromaticum has an effective inhibition of biofilm caused by quorum sensing and virulence factors against clinically isolated P. aeruginosa. Biofilm prevents the entry of antibiotics, thereby developing drug resistance. The quorum quenching phyto compounds inhibit the bacterial communication and make them less virulent might be a novel non-antibiotic therapeutic system for pathogenic bacteria. Further research is necessary to identify the bioactive compound(s) responsible for the activities.
Keywords: Quorum sensing inhibition, Biofilm, Virulence factors, Sygygium aromaticum.
© 2016 The Authors. Published by Innovare Academic Sciences Pvt Ltd. This is an open access article under the CC BY license (http://creativecommons.org/licenses/by/4.0/)
INTRODUCTION
Quorum sensing (QS), a population density dependent mechanism present in many bacteria, is mediated through auto inducers (small signal molecules) which regulate the target gene expression responsible for the phenotypes essential to pathogenicity/symbiosis leading to biofilm formation. Biofilm is the matrix of EPS serves as a protective function by reducing antibiotic efficiency thereby developing drug resistance [1]. The virulence factors produced by bacteria help to develop pathogenicity and reduce the effect of host immune system [2].
The antibiotics isolated from one bacteria being used therapeutically can independently and simultaneously induce biofilms in other bacteria by activating specific signalling pathways [3]. The antibiotics may also enhance the biofilm formation when used at sub MIC (minimum inhibitory concentration) [4]. Conventional antibiotics possess broad range efficacy via toxic or growth-inhibitory effects on target organisms. The excessive and indiscriminate usage of antibiotics has emerged in MDR (multiple drug resistant) bacterial strains which have become a growing concern worldwide [5]. Due to MDR pathogens million people die annually of infectious diseases. Not only do most antibiotic treatments fail but also an immune system has difficulties to eliminate bacteria in a biofilm [6].
Since ancient times, Indian spices have been used as medicine due to their beneficial effects against infectious diseases [7]. Recent research has revealed that few spices have the property of modulating bacterial QS system, thereby reducing the virulence [8-10]. The plant compounds usually target the bacterial QS system via different ways by stopping the signalling molecules from being synthesized, degrading the signalling molecules and/or targeting the signal receptor [11, 12]. In this scenario, the present study was aimed to investigate the effect of commonly used Indian spices on the QS and virulence factors inhibition.
MATERIALS AND METHODS
Chemicals and reagents
Azocasein, Gallic acids and Quercetin were purchased from Sigma-Aldrich (St. Louis, USA). Folin-Ciocalteu’s phenol reagent was obtained from Merck, Germany. All other chemicals used in the study were of analytical grade.
Sample collection and extraction
The spices (Syzygium aromaticum, Trigonella foenum-graecum, Cariandrum sativum, Capsicum annuum, Brassica juncea, Pipper nigrum, Papaver somniferum and Nigella sativa) were collected locally in and around Bangalore, Karnataka, India. The plant materials were identified by Dr. S. B. Sullia, Botanist and Microbiologist, Jain University. The materials were cleaned, dried and powdered. The powdered samples were extracted with methanol at 1:10 (w/v) concentrations by using Soxhlet apparatus. The extract was filtered through Whatman No.1 filter paper and the filtrate was concentrated by rotary evaporator, stored at 4 °C and used for further studies.
Strains and culture condition
Chromobacterium violaceum 12742 was procured from MTCC, Chandigarh and Pseudomonas aeruginosa, a clinical isolate was collected from Bhagawan Mahaveer Jain Hospital, Bangalore. The cultures were maintained in the LB (Luria Bertani) medium at regular intervals for further studies.
Phytochemicals screening
The extracts were subjected to the qualitative phytochemical screening according to the standard procedure [13].
Total phenol and flavonoid determination
Total phenol content was estimated using Folin-ciocalteau reagent according to Mc Donald et al.[14]and Gallic acid were used as standard for calibration curve. The total flavonoid content was quantified according to the standard procedure [15]. Quercetin was used as standard for calibration curve.
Qualitative disc diffusion assay
The disc diffusion method was employed to detect the QSI activity of the spices extracts (50,100, 150 and 200 mg/ml) and the clear zone of inhibition around the disc was measured [16].
Quantitative violacein inhibition assay
Quantitative evaluation of QSI activity of the spices was carried out based on their ability to inhibit the production of purple pigment violacein by C. violaceum and pigment production were quantified at 585 nm using UV-Vis spectrophotometer [7].
Inhibition of biofilm formation and in situ microscopic observation
Among all the tested spices S. aromaticum shown best activity analysed for further studies. The effect of S. aromaticum extracts on the biofilm formation was determined by quantifying the biomass through microtiter plate assay [17]. The clinical pathogen was incubated in 96 well plates in the presence and absence of extracts for 16 h without agitation. The free-floating plank tonic cell was removed, washed with sterile water and stained with 0.2% crystal violet solution for 15 min. The excess crystal violet was discarded, wells were filled with 95% ethanol and absorbance was measured at 650 nm using a UV-visible spectrophotometer. For in situ microscopic observation of biofilm the clinical pathogen was incubated for 16 h in 6 well plates having cover glass of one cm2 along with and without S. aromaticum extract. The free-floating plank tonic cell was removed, washed with sterile water and stained with 0.2 % crystal violet solution for 15 min. The adhered biofilms were observed under light microscopy [17].
Effect of extracts on virulence factors
Extraction and quantification of EPS
The clinical pathogen was grown in the presence and absence of S. aromaticum extract for 16 h. The incubated culture was centrifuged and the pellet was suspended in 50 ml of high-salt buffer (10 mM KPO4, pH 7. 5 mM NaCl, 2.5 mM MgSO4). The cells were removed by centrifugation and dislodged EPS was precipitated by adding three volumes of ethanol. The resulting precipitate was re suspended in an appropriate volume of double distilled water and stored at-20 °C. The extracted EPS was quantified using phenol-sulphuric acid method and absorbance was measured at 490 nm [18].
Azocasein-degrading proteolytic activity
Proteolytic activity of pathogenic bacteria was determined using Azocasein as the substrate. 150 μl of both treated and untreated pathogenic culture supernatants with S. aromaticum was added to one ml of 0.3% Azocasein in 0.05 M Tris-HC1 and 0.5 mM CaCl2 (pH 7.5) and was incubated at 37 °C for 15 min. The reaction was stopped by the addition of 0.5 ml trichloroacetic acid (l0%) followed by centrifugation and the absorbance was measured at 400 nm [19].
Pyocyanin quantification assay
The pyocyanin quantification assay was performed by inoculating the pathogenic bacteria into the pyocyanin broth (peptone–20g, MgCl2–1.4 g, K2SO4–1.0 g/l, and pH7.4) in the presence and absence of S. aromaticum extracts. After 24 h of incubation, the cells were removed by centrifugation and the broth was extracted with equal volume of chloroform and then re-extracted with one ml of 0.2 N HCl. The absorbance of the solution was measured at 520 nm [20].
Swimming assay
For swimming assay, the overnight cultures of pathogenic bacteria were point inoculated at the center of the plates containing 1% tryptone, 0.5% NaCl and 0.3% agar with and without S. aromaticum extracts. Plates were incubated for 16 h at 37 °c and the swimming migration was measured [20].
ATR-IR analysis of S. aromaticum
S. aromaticum was subjected to ATR-IR (Bruker Alpha ECO-ATR spectrometer) analysis for the functional groups. A small amount of sample was placed directly on the germanium piece of the IR spectrometer with constant pressure and wave number ranged from 4000 cm–1 to 675 cm–1. The characteristic peaks were determined according to their functional groups [21].
Statistical analysis
All the experiments were carried out in triplicates. Results were expressed as the mean±S. E (Standard Error) of three independent experiments (n=3).
RESULTS
Phytochemical analysis
The phytochemical screening of methanolic extract of Indian spices revealed the presence of tannins, flavonoids, terpenoids, cardiac glycosides, carbohydrates, alkaloids and phenolic compounds (table 1). Among all the spices, the total phenol (35±0.53 mg/GAE/g dry weight) and flavonoid (18±0.22 mg/QE/g dry weight) contents were found to be maximum in S. aromaticum (table 2).
Effect of Indian spices on QSI
The qualitative (6±0.3 mm) and quantitative (57.63±0.4%) violacein inhibition of spices revealed that S. aromaticum showed the highest inhibition at 200 mg/ml followed by C. annuum and B. juncea respectively (table 2).
Effect of S. aromaticum on P. aeruginosa
S. aromaticum extract exhibited maximum biofilm inhibition at 200 mg/ml (49.36±1.5%). In situ microscopic observation of the biofilm showed a thick layer of biofilm in control cover slips and S. aromaticum treated one exhibited concentration dependent biofilm inhibition against P. aeruginosa. The S. aromaticum showed significant effect on the virulence factors viz. EPS, pyocyanin, proteolytic and swimming motility inhibition of P. aeruginosa compared to un treated one.
Spectrometric analysis of the extracted EPS revealed that the concentration of EPS decreased with increasing concentration of S. aromaticum. The test extract exhibited 58.06±0.74% inhibition of EPS production of P. aeruginosa at 200 mg/ml. The tested extract showed maximum pyocyanin inhibition (60.15±0.43%) and the proteolytic activity (45±0.6%) at 200 mg/ml(table 2). It also exhibited significant swimming motility inhibition of P. aeruginosa at 200 mg/ml (fig. 1).
Table 1: Qualitative phytochemical screening of Indian spices
Test group |
Phenols |
Flavonoid |
Alkaloids |
Terpenoids |
Saponins |
Tannins |
Cardiac glycoside |
Carbohydrate |
B. juncea |
+ |
+ |
- |
+ |
- |
+ |
+ |
+ |
C. annuum |
+ |
+ |
- |
+ |
- |
+ |
+ |
+ |
C. sativum |
+ |
+ |
- |
+ |
- |
+ |
+ |
+ |
N. sativa |
+ |
+ |
+ |
- |
- |
- |
+ |
+ |
P. nigrum |
+ |
+ |
- |
+ |
- |
+ |
+ |
+ |
P. somniferum |
+ |
+ |
+ |
+ |
- |
+ |
+ |
+ |
S. aromaticum |
+ |
+ |
- |
+ |
- |
+ |
+ |
+ |
T. Foenum graecum |
+ |
+ |
- |
+ |
- |
+ |
+ |
+ |
+: detected; -: not detected
Table 2: Total phenolic, total flavonoid contents and QSI of Indian spices
Plant Extract |
Total phenolic content (mg/GAE/g DW) |
Total flavonoid content (mg/QE/g DW) |
Qualitative QSI (nm)at 200 mg/ml |
Quantitative QSI (%) at 200 mg/ml |
B. juncea |
17.1±0.34 |
3±0.43 |
4±0.7 |
34.75±0.5 |
C. annuum |
10±0.24 |
2.±0.57 |
5±0.4 |
42.37±0.6 |
C. sativum |
8.5±0.38 |
5±0.43 |
--- |
--- |
N. sativa |
17.9±0.53 |
7±0.67 |
--- |
--- |
P. nigrum |
17.7±0.62 |
11±0.71 |
--- |
--- |
P. somniferum |
2.6±0.22 |
1±0.63 |
--- |
--- |
S. aromaticum |
35±0.53 |
18±0.22 |
6±0.3 |
57.63±0.4 |
T. Foenum graecum |
7.5±0.45 |
2.5±0.47 |
--- |
--- |
Each value in the table is represented as mean±SD (n=3). mg GAE/gm DW: milligram gallic acid equivalent per gram dry weight mgQE/gm DW: milligram quercetin equivalent per gram dry weight

Fig. 1: Biofilm inhibition of S. aromaticum
Each value is expressed as mean±SE (Standard Error) (n=3)

Fig. 2: EPS inhibition of S. aromaticum
Each value is expressed as mean±SE (Standard Error) (n=3)

Fig. 3: Proteolytic activity of S. aromaticum
Each value is expressed as mean±SE (Standard Error) (n=3)

Fig. 4: Pyocyanin inhibition of S. aromaticum
Each value is expressed as mean±SE (Standard Error) (n=3)
Fig. 5: Swimming inhibition of S. aromaticum on P. aeruginosa
Where; A= Control, B= S. aromaticum at 200 mg/ml
ATR-IR analysis of S. aromaticum
ATR-IR analysis of S. aromaticum confirmed the presence of hydroxyl, alkynes, anhydrites, alkene, nitro, aromatics, esters, sulfoxide and halogen functional groups with major peaks at3459.059, 2965.49, 1764.202, 1625.513, 1501.101, 1260.435, 1201.289, 1038.126and 611.8618 cm-1 respectively (fig. 6).

Fig. 6: ATR-IR analysis of TLC bioactive fraction of S. aromaticum
DISCUSSION
Ayurveda is originated in India and known as the oldest traditional systems medicine with more than2000 therapeutic plant species. Screening of medicinal plants for their bioactivity is important since traditional medicines are used as complementary and alternative medicine widely throughout the world. [22]. Herbs and spices are common ingredients as flavouring and preservative in food preparation among the Indians. These are also used as preventive and curative medicines. Agaoglu et al. [9] reported that the antibacterial activity of spices Cinnamomum zeylanicum, Syzygium aromaticum and Cuminum cyminum against Gram negative and Gram positive bacteria.
In the current study, the phyto chemical screening of spices revealed the presence of tannins, flavonoids, terpenoids, cardiac glycosides, carbohydrates, alkaloids and phenolic compounds. Quantitatively total phenolic contents are prevalent in all the eight Indian spices compared to other phyto chemicals ranging from 2.6-35 mg/GAE/g DW. Among all the extracts, S. aromaticum possesses highest total phenolic and flavonoid contents (table 2).
Very few reports are available related to the quorum sensing inhibition of Indian spices [16, 17, 22]. In the present study, S. aromaticum exhibited highest quorum sensing inhibition in comparison to all the tested spices and analysed for further studies. S. aromaticum showed concentration dependent violacein pigment inhibition on C. Violaceum which is in accordance with Khan et al. [16]; Krishnan et al. [22]. The in situ microscopic observation of biofilm inhibition showed dose dependent inhibition of biofilm formation [17]. The EPS formation was inhibited by S. aromaticum which indicates that the bacterium was unable to attach to host for the formation of biofilms and susceptible to host immune system leading to the eradication of the plankton bacterium. The virulence factors viz. pyocyanin, proteolytic and swimming motility helps the bacterium to promote the pathogenicity and acts against the host immune system. The S. aromaticum showed significant inhibition of above virulence factors, thereby inhibiting spreading of the disease and thus helps the host immune system. The above findings are in accordance to the earlier investigations [17, 22, 23]. The ATR-IR analysis of spectra showed the presence of alkanes, alkynes, aldehydes, aromatics, carboxylic acids and halogen groups.
CONCLUSION
It is concluded that S. aromaticum exhibited an effective inhibition of biofilm and virulence factors against clinically isolated P. aeruginosa. The ATR-IR analysis of S. aromaticum showed the presence of phyto constituents with functional groups which might be responsible for the quorum sensing, biofilm and virulence factors inhibitory activities of S. aromaticum .
ACKNOWLEDGEMENT
The authors are grateful to the Jain University for providing infrastructure for carrying out the research work. We thank Dr. Geetha V Bhat, Microbiologist and Infection control officer, Bhagwan Mahaveer Jain Hospital, Bengaluru for providing Pseudomonas aeruginosa strain. We also thank Dr. Geetha Balakrishna, Director, CNMS, Jain University, for ATR-IR spectra analysis.
CONFLICT OF INTERESTS
Declared None
REFERENCES
- Vasavi HK, Arun AN, Rekha PD. Inhibition of quorum sensing in Chromobacterium violaceum by Syzygium cumini L. and Pimenta dioica L. Asian Pac J Trop Biomed 2013;3:954-9.
- Beceiro A, María T, Germán B. Antimicrobial resistance and virulence: a successful or deleterious association in the bacterial world? Clin Microbiol Rev 2013;26:185-230.
- Bleich R, Jeramie DW, Pieter CD, Albert AB, Elizabeth AS. Thiopeptide antibiotics stimulate biofilm formation in Bacillus subtilis. Proc Natl Acad Sci 2015;112:3086-91.
- Kaplan JB. Antibiotic-induced biofilm formation. Int J Artif Organs 2011;34:737-51.
- Ciofu O, Giwercman B, Pedersen SS, Høiby N. Development of antibiotic resistance in Pseudomonas aeruginosa during two decades of antipseudomonal treatment at the Danish CF Center. Acta Pathol Microbiol Immunol Scand 1994;102:674-80.
- Conley J, Olson ME, Cook LS, Ceri H, Phan V, Davies HD. Biofilm formation by group A Streptococci: is there a relationship with treatment failure. J Clin Microbiol 2003;41:4043-8.
- Chenia H. Anti-Quorum sensing potential of crude Kigelia africanafruit extracts. Sensors 2013;13:2802-17.
- Adonizio AL, Downum K, Bennett BC, Mathee K. Anti-quorum sensing activity of medicinal plants in southern Florida. J Ethnopharmacol 2006;105:427–35.
- Agaoglu S, Dostbil N, Alemdar S. Antimicrobial activity of some spices used in the meat industry. Bull Vet Inst Pulawy 2007;51:53-7.
- Asha D, Umasankar ME, Babu S. A comperative study of anti-oxidant properties in common Indian spices. Int Res J Pharm 2012;3:465-9.
- Manefield M, Welch M, Givskov M, Salmond GP, Kjelleberg S. Halogenated furanones from the red Alga, Delisea pulchra, inhibit carbapenem antibiotic synthesis and exoenzyme virulence factor production in the phytopathogen Erwinia carotovora. Fems Microbiol Lett 2001;205:131-8.
- Hentzer M, Riedel K, Rasmussen TB, Heydorn A, Andersen JB, Parsek MR, et al. Inhibition of quorum sensing in Pseudomonas aeruginosa biofilm bacteria by a halogenated furanone compound. Microbiology 2002;148:87-102.
- Harborne JB. Photochemical methods: a guide to modern techniques of plant analysis. Chapman Hall 1973;2:279-83.
- McDonald S, Prenzler PD, Antolovich M, Robards K. Phenolic content and antioxidant activity of olive extracts. Food Chem 2001;73:73-84.
- Nguyen Q, Eun J. Antioxidant activity of solvent extracts from Vietnamese medicinal plants. J Med Plants Res 2011;5:2798-811.
- Khan MSA, Zahin M, Hasan S, Husain FM, Ahmad I. Inhibition of quorum sensing regulated bacterial functions by plant essential oils with special reference to clove oil. Lett Appl Microbiol 2009;49:354-60.
- Husain FM, Iqbal A, Mohammad QT. Influence of clove oil on certain quorum-sensing-regulated functions and biofilm of Pseudomonas aeruginosa and Aeromonas hydrophila. J Biosci 2013;38:835-44.
- Issac ASVP, Agilandeswari P, Babu RR, Karutha PS, Veera RA. Anti-quorum sensing and antibiofilm potential of Capparis spinosa. Arch Med Res 2011;42:658-68.
- Annapoorani A, Balaji K, Khadar SM, Shunmugiah KP, Arumugam VR. Antipathogenic potential of Rhizophora spp. against the quorum sensing mediated virulence factors production in drug resistant Pseudomonas aeruginosa. Phytomedicine 2013;8:132-43.
- Weihua C, Shuxin Z, Yan J, Wei Z, Xiyi Z, Jiangyan F. Effect of traditional Chinese herbal medicine with anti-quorum sensing activity on Pseudomonas aeruginosa. J Evidence-Based Complementary Altern Med 2013;2:1-7.
- Beatriz RL. Attenuated total reflectance spectroscopy of plant leaves: a tool for ecological and botanical studies. New Phytol 2006;172:305-18.
- Krishnan T, Wai FY, Kok GC. Inhibition of quorum sensing-controlled virulence factor production in Pseudomonas aeruginosa PAO1 by Ayurveda spice Clove (Syzygium aromaticum) bud extract. Sensors 2002;12:4016-30.
- Brackman G, Hillaert U, Van Calenbergh S, Nelis HJ, Coenye T. Use of quorum sensing inhibitors to interfere with biofilm formation and development in Burkholderia multivorans and Burkholderia cenocepacia. Res Microbiol 2009;160:144–51.